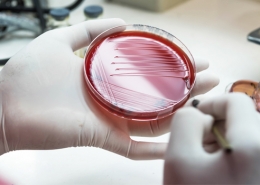
meningitis

EL BLOG DE ROIGSAT
¿Y a ti, qué te hace sentirte bien? ¿Llevar una vida saludable? ¿Reciclar los materiales de la mejor manera posible? ¿Ahorrar en el consumo energético? A nosotros, estar a tu lado siempre que lo necesites. Llevamos más de 45 años ofreciendo servicio de asistencia técnica a vuestros hogares. Y, porque nos preocupa vuestro bienestar, os hemos preparado esta sección con consejos, noticias y novedades del mundo de la ecología, el reciclaje y el ahorro.
En el blog de RoigSat hablaremos de todos estos temas. Porque juntos estaremos #ComoEnCasaEnNingunaParte.